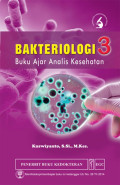
image

Biokimia : Teknik penelitian
- Edisi
- -
- ISBN/ISSN
- 978-979-075-591-8
- Deskripsi Fisik
- xvi, 256 hlm. : 25 cm
- Judul Seri
- -
- No. Panggil
- 572 BIN b
- Edisi
- -
- ISBN/ISSN
- 978-979-075-591-8
- Deskripsi Fisik
- xvi, 256 hlm. : 25 cm
- Judul Seri
- -
- No. Panggil
- 572 BIN b

Biokimia : Teknik penelitian Edisi 2
Biokimia merupakan bidang yang menjadi dasar dalam banyak mata pelajaran dan selalu terkait dalam teknik penelitian yang mencakup sistem kehidupan. Untuk mengisi kekosongan buku tentang teknik pene…
- Edisi
- 2
- ISBN/ISSN
- 978-602-434-646-1
- Deskripsi Fisik
- -
- Judul Seri
- -
- No. Panggil
- 572 BIN b
Hasil Pencarian
Ditemukan 2 dari pencarian Anda melalui kata kunci: Pengarang : Maria Bintang
Permintaan membutuhkan 0.00106 detik untuk selesai
Karya Umum
Karya Umum  Filsafat
Filsafat  Agama
Agama  Ilmu-ilmu Sosial
Ilmu-ilmu Sosial  Bahasa
Bahasa  Ilmu-ilmu Murni
Ilmu-ilmu Murni  Ilmu-ilmu Terapan
Ilmu-ilmu Terapan  Kesenian, Hiburan, dan Olahraga
Kesenian, Hiburan, dan Olahraga  Kesusastraan
Kesusastraan  Geografi dan Sejarah
Geografi dan Sejarah